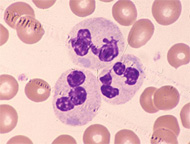
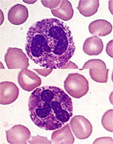
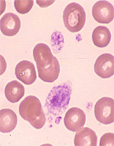

ここで白血球の形態異常を整理しましょう。
先天性と後天性(敗血症、MDS)が代表的です。①核の異常、②細胞質の異常、③顆粒の異常に分けられます。
 Pelger-Huët異常 |
May-Hegglin異常 |
Alder-Reilly異常 |
 Jordans異常 |
 Chédiak-Higashi異常 |
May-Hegglin異常 |
